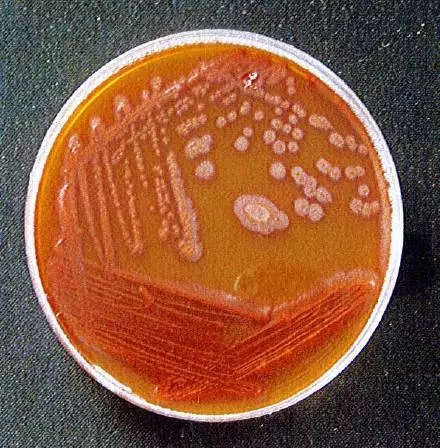

超纯水系统的微生物多样性研究

近期,浙江省微生物技术与生物信息学重点实验室陈欢团队与中核核电运行管理有限公司合作,在《核动力工程》杂志(EI收录)中发表了核电站主泵轴封水系统微生态研究的成果。
为了系统的研究主泵轴封水系统的微生态,根据其封水系统特征对选出的21个点的水样进行了微生物检测。微生物培养的结果显示来自水源点的菌落总数最高。利用MPN法测定铁细菌和硫酸盐还原菌的结果表明了系统中主要的微生物类型为铁细菌,对其部分培养菌种鉴定后发现为不动杆菌、假单胞菌、罗尔斯通氏菌等。
堵塞物微生物在铁细菌培养基上的生长情况
针对其中的4个优势物种,包括不动杆菌1(Acinetobacter radioresistens),不动杆菌2(Acinetobacter sp.),纳西菌(Naxibacter haematophilus)和假单胞菌(Pseudomonas sp.)进行温度和抗生素敏感性实验,结果表明,4个菌株在正常的生长条件下,对75℃以上温度和青霉素、氯霉素都敏感。

为进一步揭示超纯水系统的微生物种类,我们还利用宏基因组的思路对21个点的不经培养,直接测序,鉴定结果又发现了一些难培养的细菌类型,主要为慢生根瘤菌、丛毛单胞菌、鞘氨醇单胞菌、栖热菌等。这些菌大部分为寡营养细菌,可以在营养极度缺乏的条件下存活,如罗尔斯通氏菌和假单胞菌可以形成生物膜,同时不动杆菌的存在又可以促使这些细菌形成集聚,从而形成的抗逆的微生物胶状复合体造成管道的堵塞。
研究结果证实了核电站的主泵轴封水系统的堵塞是多种菌共同作用的结果,要降低微生物腐蚀的副作用,必须破坏这类微生物的共生效应,定期的监控和消杀(高温、杀菌等)可以降低堵塞的风险。

